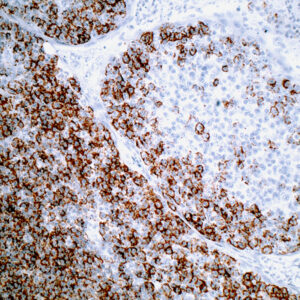
Anti-CD3 (T cell)

Both
Showing 621–640 of 703 resultsSorted by latest
-

Anti-BCL-2 Oncoprotein
Price range: $260.00 through $1,619.00 Select options This product has multiple variants. The options may be chosen on the product page -

Anti-Cytokeratin cocktail, broad spectrum
Price range: $250.00 through $935.00 Select options This product has multiple variants. The options may be chosen on the product page -

Anti-CD11b/ITAM
Price range: $269.00 through $1,075.58 Select options This product has multiple variants. The options may be chosen on the product page -

Anti-CD71 (transferrin Receptor)
Price range: $250.00 through $796.72 Select options This product has multiple variants. The options may be chosen on the product page -

Anti-CD56 (Natural Killer Cell, NCAM)
Price range: $217.00 through $730.00 Select options This product has multiple variants. The options may be chosen on the product page -

Anti-CD21
Price range: $250.00 through $715.00 Select options This product has multiple variants. The options may be chosen on the product page -

Anti-CD8
Price range: $143.69 through $702.82 Select options This product has multiple variants. The options may be chosen on the product page -
Anti-CD3 (T cell)
Price range: $154.00 through $725.00 Select options This product has multiple variants. The options may be chosen on the product page -

Anti-Cytokeratin 7
Price range: $260.00 through $1,430.00 Select options This product has multiple variants. The options may be chosen on the product page -

Anti-Cytomegalovirus (CMV)
Price range: $250.00 through $923.00 Select options This product has multiple variants. The options may be chosen on the product page -

Anti-Proliferating Cell Nuclear Antigen (PCNA)
Price range: $260.00 through $935.00 Select options This product has multiple variants. The options may be chosen on the product page -

Anti-Cytokeratin 19
Price range: $250.00 through $1,195.00 Select options This product has multiple variants. The options may be chosen on the product page -

Anti-Dystrophin 2
Price range: $350.00 through $995.00 Select options This product has multiple variants. The options may be chosen on the product page -

Anti-CD31 (PECAM-1)
Price range: $250.00 through $1,165.00 Select options This product has multiple variants. The options may be chosen on the product page -

Anti-p53 Protein
Price range: $250.00 through $1,249.00 Select options This product has multiple variants. The options may be chosen on the product page -

Anti-p53 Protein
Price range: $260.00 through $1,349.00 Select options This product has multiple variants. The options may be chosen on the product page -

Anti-CD20 (B cell)
Price range: $269.00 through $1,195.00 Select options This product has multiple variants. The options may be chosen on the product page -

Anti-CD34 (Endothelial Cell)
Price range: $260.00 through $1,439.00 Select options This product has multiple variants. The options may be chosen on the product page -

Anti-CD31 (Endothelial Cell)
Price range: $260.00 through $1,195.00 Select options This product has multiple variants. The options may be chosen on the product page -

Anti-B Lymphocyte Antigen 36, BLA-36
Price range: $312.00 through $945.00 Select options This product has multiple variants. The options may be chosen on the product page
